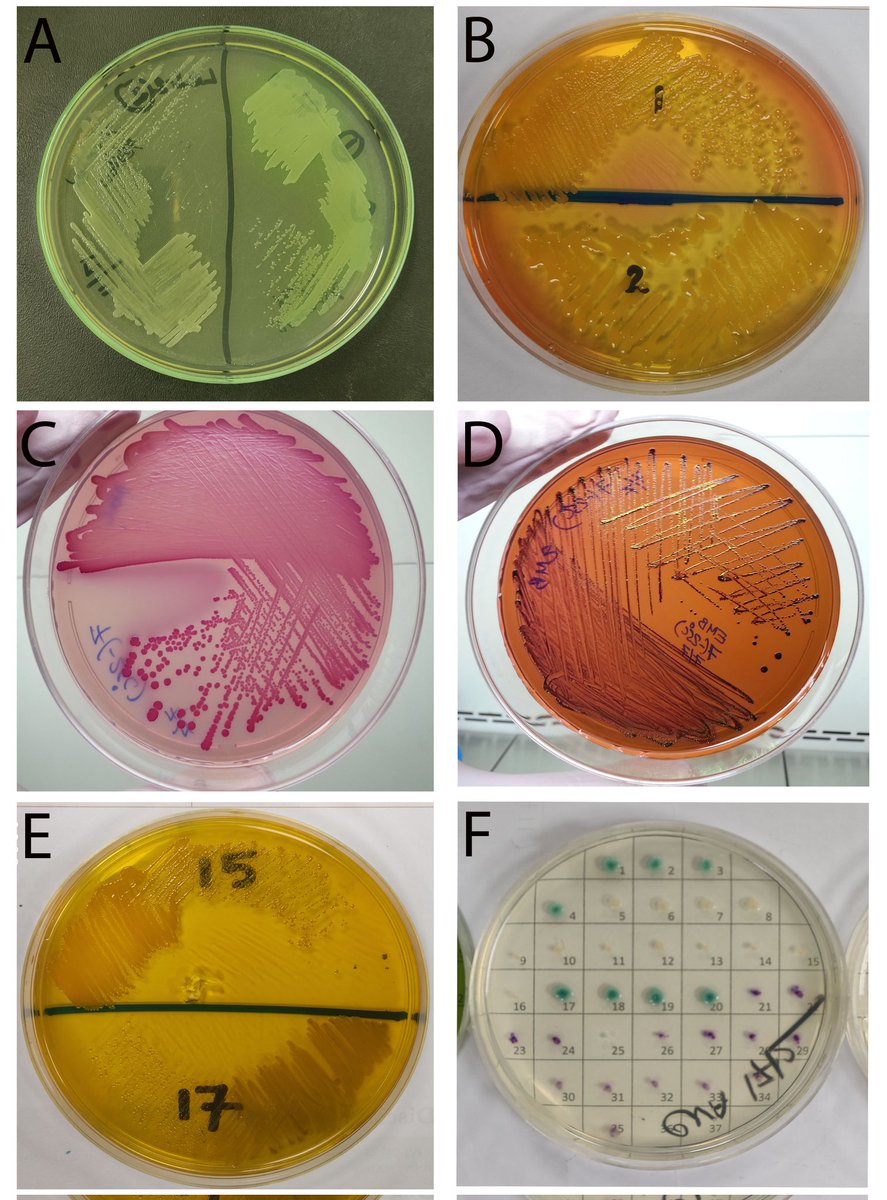
Occurrence of #multiantibioticresistantbacteria isolated from #foodhandlers’ hands and #utensils at different #restaurants in Dhaka, #Bangladesh

doi.org/10.5455/jabet.…

JABET Editorial Office
@jabeteditor
Its an open access, international, peer-reviewed, triannually, scientific journal on all aspects of biotechnology and experimental therapeutics.
ID: 969566997875908609
http://www.bsmiab.org/jabet/ 02-03-2018 13:36:00
448 Tweet
47 Takipçi
292 Takip Edilen